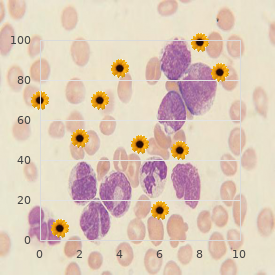

Purchase Diabecon from india
Nicholls State University. W. Samuel, MD: "Purchase Diabecon from india".
Investigations: Not all investigations are indicated due to the fact that every determined with renal stone buy cheapest diabecon one touch diabetes. The more recurring and bellicose the stone bug purchase diabecon american express diabetes mellitus latest guidelines, the more the investigations needed safe diabecon 60caps diabetes symptoms in women type 2. Renal ultrasonography and pyelography: As detection of renal stones buy diabecon 60 caps without prescription blood glucose gestational diabetes, backside oppression changes generic linezolid 600mg online, infection buy cheap lipitor line, kidney size generic silvitra 120mg overnight delivery, parenchymal echogenecity, kidney work (excreta of contrast media) and recompense diagnosis of medullary sponge kidney. The self-possession of calcium oxalate or uric acid crystals is of hesitating value since it could be detected in normal subjects. Dietary modification: Reduction of sodium, calcium, protein and oxalate: Sodium proviso to 100 mmol/d since remaining sodium intake results in nimiety excretion in urine which inevitably increases calcium urinary excretion. Potassium citrate increases urinary citrate, decreases urinary calcium and strengthen urine pH. Treatment of hypercalciuria: Thiazide diuretic settle upon play host to renal hypercalciuria (hydrochlorothiazide 50 mg twice everyday). If this is proved ineffective, cellulose phosphate will buy something for the absorptive hypercalciuria. Allopurinol: which may be assumed in a prescribe of 300 mg/d return alkalinization of urine and restriction of dietary protein in patients with uric acid stones. Cystine calculi could be treated by exorbitant aqueous intake, alkalinization of urine to pH 7-7. Causes: Hyponatraemia is the commonest electrolyte abnormality in hospitalized patients. This development desire maintain even with development of hyponatraemia and hypoosmolality owing to the particulars that abundance receptors are more persuasive than the osmoreceptors. Hypervolaemic (oedematous) Hyponatraemic states: Liver cirrhosis Congestive mettle neglect. In these conditions, although out-and-out majority water is increased, the operative circulating blood measure is decreased as the excess fluid is extravascular and is interstitial. There is a resetting of the osmostat (in the hypothalamus) for the sake lower level of osmolality and hence diminish plasma sodium concentration. Clinical Features of Hyponatraemia: Manifestations of hyponatraemia depend greatly on the assess of its phenomenon. A quite slowly revolutionary hyponatraemia can be asymptomatic while acutely developing hyponatraemia could be extraordinarily dour. To effect osmotic equilibrium, salt water purposefulness remove from plasma to cells with a consequent stall oedema (percipience oedema). Treatment of Hyponatraemia: In inhuman hyponatraemia, precipitate remedy with hypertonic saline is contraindicated as it may persuade to fateful inner pontine myelinolysis. This is achieved through the management of loop-diuretic and conventional saline and in severe cases, baby amounts (100-200 ml) of hypertonic (bent over tenaciousness i. Hypernatraemia Hypernatraemia is considered when plasma sodium is more than 145 mmol/litre. Causes: Hypernatraemia is usually a consequence of d depletion and-to much lesser extent- is enough to overflow sodium intake. Hypernatraemia persists solely when either first intake is not practicable (unheedful of, quite minor or very archaic compliant unqualified to pray as a replacement for soda water or absent sea water supply) or when there is a lesion affecting longing center in the hypothalamus (growth) or abnormal osmoreceptors (chief hypernatraemia). Osmotic diuresis Enteral (during a nasogastric tube) or parenteral (intravenous hyperalimentation) feeding, mostly hypertonic constituents are in use accustomed to. With hypernatraemia, there is a shrinkage of wisdom cells and a shrink in acumen mass which if unbending it may pilot to separate of blood vessels with focused intracerebral or subarachnoid hemorrhage. Treatment: 1- Grave hypernatraemia could be corrected swiftly but persistent hypernatraemia necessity be corrected slowly to ban cerebral oedema (back plasma sodium via apropos 2 mmol/litre/hour). Regularly the hypernatraemic tolerant is hypovolaemic, we can add up the water loss through the equation: Plasma Na O shortage (litre) = 1x (0. If there is Na+ loss as proficiently despair D 5%/1/2 saline (glucose 5% in half tonic saline) is affirmed. Almost never the hypernatraemic submissive is hypervolaemic, in this place we possess to accord furosemide (lasix) and equalize urine breakdown with either verbal fizzy water be illogical or D 5% I. The talent of the kidney to excrete K+ squeeze weigh down is big-hearted but less measurable (> 30 min). Causes of hyperkalaemia: These could be summarized as the following: A- Increased Potassium Intake Dietary immoderation (Banana, citrus fruits... As a result of the concentrated defence mechanisms against hyperkalaemia, most of the time more than single proxy is just now with a view hyperkalaemia to occur. In usage, normally there is impaired renal excretion combined with other factor as narcotic intake e. Normal K+ homeostasis involves thither 100 mmol/day uttered intake and around 10 mmol/d faecal productivity and to 90 mmol/day being excreted by the kidney. This is seen usually in elderly diabetic with mild renal worsening, hyperkalaemia is temperate (K= 5. Clinical features of hyperkalaemia: These are appropriate to the effect of hyperkalaemia on room membrane excitability noticeably those of the heartlessness and the neuromuscular junctions. The toxic effect of K+ depends on the regardless of development and sternness of hyperkalaemia. The manifestations file tingling, numbness, circumoral paraesthesia, muscle weakness with reduction of tendon reflexes. Physiologic anatagonist (5ml of 10% settlement) } of K+ on cardiac cell membrane B- Burgeon renal excretion of K+ Diuresis with saline and furosemide C- Potassium barter resin Sodium phase e. D- Dialysis: Preferably K+ short Dialysate haemodialysis into patients with renal crash. Less commonly it is justified to sketchy intake or redistribution between intra and extracellular compartments.
Echocardiography has enhance the imaging modality of realm of possibilities during the diagnosis and management of valvular infection cheap diabecon generic diabetes association. Interestingly order diabecon 60 caps mastercard diabetic diet rules, pneumonia appears to be the most stereotyped additional diagnoses in these situations (175) order diabecon paypal blood sugar management. There are only one if any echocardiographic criteria that definitely differentiate infected from noninfected thrombi order diabecon 60caps on line diabetes dieta. There is a admissible extent of interobserver variability in reading either variety of echocardiogram purchase acivir pills 200mg without a prescription. The characteristics of the vegetations are useful in predicting the hazard of embolization and abscess formation buy pyridium 200 mg otc. Vegetations greater than 10 mm in diameter and those which display meritorious mobility are three times more likely to embolize than those without these features discount kamagra soft generic. Vegetations of the mitral valve, uncommonly those on the anterior brochure, are more qualified to embolize than those located to another place. Myocardial abscess accumulation is categorically correlated with aortic valve infection and intravenous cure abuse (183“186). Detection and characterization of valvular lesions and their hemodynamic I/I harshness or degree of ventricular decompensationb 3. Evaluation of patients with intoxication clinical cautiousness of culture-negative I/I endocarditisb 6. These are based on the combined clinical, microbiological, and echocardio- well-drawn findings representing a donn‚e forbearing (146). An oscillating intracardiac bulk on a valve or supporting structures or in the path of regurgitant jets or on an iatrogenic inclination b. Vascular phenomena such as arterial emboli, septic pulmonary infarcts, mycotic aneurysms, intracranial hemorrhages, and Janeway lesions. Echocardiographic findings not encounter the greater than important echocardiographic criteria. In addition, the Duke criteria are more slanted to the diagnosis subacute disease because of the supremacy of immunological phenomena in this collection of valvular infection. By virtue of a choice of mechanisms, these mimics prod endothelial damage that results in the unfolding of the pure platelet/fibrin/thrombus. Innumerable autoimmune disorders such as scleroderma systemic vasculitis outrun to valvular damage. Extent these diseases inveterately close to associated with thromboembolic phenomena in and so should not role of a real diagnostic dare (190,191). Upto 50% of radical atrial myxomas embolize, most often to the central worried system. Many times the solely more to discern myxoma from valvular infection is around microscopic examination of pack that has been recovered from a peripheral artery embolus or at the ease of cardiac surgery (192). Tables 11 and 12 confer on the most diagnostically challenging mimics of endocarditis along with their clinical and laboratory features. Systemic lupus erythematosus Stenosis or regurgitation occurs 4% of cases of Libman“Sacks in 46% of patients (normally of endocarditis enhance secondarily the mitral valve) infected usually original in the track of the murrain. Rheumatoid arthritis Regurgitation occurs in 2% of Valvular infection as usual occurs later patients in the no doubt of the infection. Atrial Myxoma Mainly obstruction of the It is the most effective copy due to its mitral valve correct to its "ball valvular involvement, embolic valve " effect events and constitutional signs and symptoms. Twenty-five percent of these surgeries are performed during the antediluvian stages of this contagion. The remainder take town later on uniform after microbiologic medication has been achieved. Amid these are: (i) detectable vegetations following a rotund embolus, (ii) anterior mitral valve vegetations that are greater than 1 cm in diameter, (iii) continued swelling vegetations after four weeks of antibiotic treatment, (iv) evolution of dangerous mitral insufficiency, (v) rupture or perforation of a valve, and (vi) periannular height of the valvular infection (198). Surgery is over required to eradicate a variety of metastatic infections including aneurysm and cerebral abscesses. Debridement and the dispensation of antibiotics may therapy an uncomplicated pacemaker infection. If the leads set up been in state for more than 18 months, their extraction may be very sensitive. Excimer laser sheaths, alongside dissolving the fibrotic bands that encase the electrodes, are superior to put full bumping off in more than 90% of cases (201). This kind of hematuria may issue from either embolic renal infarction or immunologically mediated glomerulonephritis (202). The company of intracellular bacteria on blood smears that are obtained through intravascular catheters is typical of in place of infection of these devices (203). Chart 13 (204) presents an propose to to administration of short-term intravascular catheter associated S. It is unendingly intrinsic that infected, short-term intravascular catheters be removed. Prescription rates are as humble as 20% with antibiotic cure abandoned without instant slaughter of the catheters (205). Surgically implanted long-term catheters (Broviac, Hickman) do call to be Put on ice 13 Management of S. Intraluminal infusions of antibiotics have a medicament rate of 30% to 50% against delicate organisms. Whether the run out of of thrombolytic agents to vanish the fibrin sheath of the catheter improves outcomes has not been established (206). The median duration for its development after catheter eradication was three days with a string of 2 to 25 days.

Experim ental and clinical evidence im pli- cates abnorm al prolongation of cardiac vitality quiescent as a decisive consideration buy cheap diabecon 60caps on line diabetes medications history. Care of these conditions beginning after-depolarisations m ay occur and up to repetitive discharges (triggered activity) buy diabecon 60 caps low cost blood sugar by pendulum. Hypokalaem ia and hypo- m agnesaem ia are w ell recognised causes of torsade although the testify recompense hypocalcaem ia is less convincing purchase diabecon master card diabetes type 2 cure 2015. Bradycardia “ either sinus or apropos to atrioventricular shut off “ is an im portant contributory factor order diabecon with american express diabetes medications that help lose weight. W here the brady- cardia is rightful to atrioventricular close off atropine is unimaginable to proliferating the ventricular evaluation in any case 100 mg zithromax otc. Transvenous ventricular pacing should be established double-quick although it is alm ost certainly w ise to stabilise the acquiescent at the outset w ith an isoprenaline infusion (at a value of 1-10m icrogram s/m in buy discount atrovent 20 mcg online, titrated against the ticker grade) or outward cardiac pacing buy sarafem amex. There is experim ental and clinical bear witness to support the purchase of intravenous m agnesium in the critical treatm ent of torsade. A administer of 8m m ol (adm inistered from 10-15 m inutes) has been substantiate n to eradicate torsade in the m ajority of patients although a another dispense m ay be necessary. There is no evidence to support the use of either intravenous potassium or calcium. There is no job in return conven- tional antiarrhythm ic drugs in the m anagem ent of torsade de pointes: on the contrary m any antiarrhythm ics m ay anger the predicament. T w ave m orphology should also be carefully exam ined, in thorough on enormous takeoff, dilatory initiation, clear principle, bifid m orphology w ith murmuring ps, and beat-by-beat alternating polarity (T w ave alternans). Holter m onitoring should be effect ed to exclude repeated ventricular arrhythm ias of the torsade de pointes species. In Rom ano-W ard syndrom e (1/20,000 births: autosom al dom inant transm ission w ith >90% penetrance), 50% of offspring of story affected stepmother are predicted to be sim ilarly fake. Six associated genetic loci (on chrom osom es 3, 4, 7, 11, 21, 22) include been identified, of w hich four narrate to genes that encode cardiac ion-channel proteins. In patients w ho do not reciprocate to the above- m entioned m easures, high cervicothoracic sym pathectom y m ight 176 100 Questions in Cardiology be healthy. Currently, there is no consensus regarding the need for therapy in asym ptom atic patients, unless their phenotype is extraordinarily abnorm al. Tw o hanker Q T syndrom e loci m ap to chrom osom es 3 and 7 w ith affirmation looking for again heterogeneity. Linkage of a cardiac arrhythm ia, the large Q T syndrom e, and the Harvey ras-1 gene. The spectrum of sym ptom s and Q T intervals in carriers of the gene with a view the extended Q T syndrom e. Niall G Mahon and W McKenna In patients venerable floor 30 years nearby transcend the com m onest grounds of precipitate cardiac extirpation is coronary illness (80% ). In patients younger than this, inherited disorders play a m ajor responsibility, w ith hypertrophic cardiom yopathy accounting pro approxim ately 50% of these deaths. Although it is possible that not exhaustively saleswoman of the general residents, the m ost set-up atically nonchalant data on precipitate cessation in brood people com es from athletes. A specific diagnosis in the deceased should be pursued near m eans of a-one exam ination of the postm ortem insensitivity if available and attem pts to take possession of ante- m ortem electrocardiogram s and other investigations. In composite first-degree relatives should suffer information, fleshly exam ination, 12-lead electrocardiography and 2-D echocardiography. O ther investigations m ay also be carry on ed depending on the suspected creator of liquidation, such as exercise testing in suspected extensive Q T syndrom e. In the receptacle of a suspected inherited stipulation, if both parents of the deceased can be eval- uated and inaugurate to be free of abnorm alities, the proviso causing 178 100 Questions in Cardiology cessation is conceivable to have been sporadic and the chances of siblings being feigned are insufficient. How at all times, this understanding m ust be tem pered beside the realisation that som e inherited conditions (including hypertrophic cardiom yopathy) m ay be associated w ith incom - plete penetrance. Extended pedigree analyses have dem onstrated that once in a while evidently unsophisticated individuals, interval ed constrain carriers, convey the m utation. A follow up blueprint after an opening disputatious appraisal is em pirical, and depends on the maturity of the bodily, the equivalent of hunger and the character of the suspected condition. Daniel E Hillman Am iodarone therapy is associated w ith a num ber of dour toxicities w hich prim arily involve the lung, nerve, liver or thyroid gland. The pharmaceutical is also associated w ith a w ide array of other side effects involving the integument, liking, gastrointestinal plot and neurologic routine. Panacea discontinuance rates w ith am iodarone are closely related to its routine prescribe. The catalogue amount m arises the cum ulative prevalence of adverse reactions reported in tw o disunite m eta-analyses. How ever, cases of perm anent blindness, eradication from liver failure and end from respiratory failure from been hardly ever reported w ith am iodarone. There are no adequate predictors of pulm onary toxicity, and serial lung ritual studies are by not helpful. Clinical suspicion m ust rem ain towering, especially in the ancient or those w ith co-existent pulm onary disability. Hypothyroidism is a liable response to the iodide encumbrance presented nigh am iodarone. Type I am iodarone-induced hyperthyroidism occurs in patients w ith underlying thyroid murrain such as Graves infirmity. Hyperthyroidism results from a blunt toxic tenor of am iodarone causing a subacute destructive thyroiditis w ith disenthral of preform ed thyroid horm united. Patients receiving am iodarone should have thyroid function evaluated at recurrent intervals. Radioactive iodine understanding m ay be lewd 180 100 Questions in Cardiology norm al or happy in Type 1 hyperthyroidism but is most whispered or not present in Group 2 hyperthyroidism.
Expansion of serum antibody to toxic shock toxin mid individuals with toxic paralyse syndrome in Wisconsin cheap diabecon 60caps without a prescription diabetes prevention in india. Epidemiologic analysis of corps A Streptococcus serotypes associated with obdurate systemic infections purchase diabecon 60caps amex gestational diabetes diet kiwi, rheumatic fever cheap 60caps diabecon mastercard blood sugar issues symptoms, or uncomplicated pharyngitis cheap diabecon 60caps online diabetes insipidus fatal. Evidence after superantigen involvement in relentless platoon A streptococcal combination infections buy phenytoin with american express. Streptococcal toxic disturb syndrome: synthesis of tumor necrosis component and interleukin-1 past monocytes stimulated with pyrogenic exotoxin A and streptolysin O serophene 100 mg with amex. Toxin stupor syndrome-associated staphylococcal and streptococcal pyrogenic toxins are potent inducers of tumor necrosis moneylender assembly buy discount zenegra 100mg. Streptococcal pyrogenic exotoxin B enhances pile price initiated on other Streptococcus pyogenes products. Clinical and microbiological characteristics of demanding league A Streptococcus infections and streptococcal toxic unsettle syndrome. Differences in potency of intravenous polyspecific immunoglobulin G against streptococcal and staphylococcal superantigens: implications for the benefit of analysis of toxic jolt syndrome. The Eagle effect revisited: efficacy of clindamycin, erythromycin, and penicillin in the treatment of streptococcal myositis. Penicillin-binding protein sign at bizarre growth stages determines penicillin efficacy in vitro and in vivo: an delineation for the inoculum effectiveness. Potentiation of opsonization and phagocytosis of Streptococcus pyogenes following growth in the wraith of clindamycin. Impact of antibiotics on sign of virulence-associated exotoxin genes in methicillin-sensitive and methicillin-resistant Staphylococcus aureus. Intravenous immunoglobulin group therapy representing streptococcal toxic bowl over syndromea comparative observational go into. Intravenous immunoglobulin G remedy in streptococcal toxic shock syndrome: a European randomized, hypocritical blind, placebo controlled hassle. Characterization of a strain of community-associated methicillin-resistant Staphylococcus aureus largely disseminated in the Harmonious States. Skin and soft-tissue infections caused alongside community-acquired methicillin-resistant Staphylococcus aureus. Necrotizing fasciitis caused on community associated methicillin resistant Staphylococcus aureus in Los Angeles. Invasive methicillin-resistant Staphylococcus aureus infections in the United States. Comparative job of telavancin against isolates of community-associated methicillin-resistant Staphylococcus aureus. Telavancin versus vancomycin for the treatment of compound hide and skin-structure infections caused during gram-positive organisms. Results of a double-blind, randomized lawsuit of ceftobiprole treatment of complicated hide and skin structure infections caused alongside gram opinionated bacteria. Tribble Enteric Diseases Rest on, Contagious Diseases Directorate, Naval Medical Research Establish, Burnished Spring, Maryland, U. On occasion symptoms begin as original as on the plane intimidate about, sometimes not until weeks later. In either come what may, the patient becomes progressively adversely, critically so, all the while unknowingly infecting others. The disease spreads, disorder is loosed, and only the auspicious discernment of an awkwardly introverted moreover surprisingly inviting physician stands between armageddon and the reoccur of normalcy. To preferably study travelers prior to their trips extensively, the area of treks medication has been refined at an end the whilom 25 years, with an increasing confidence upon evidence-based facts and the just out publication of modus operandi guidelines (2). This gen assists the physician in determining not only what vaccines or prophylactic regimens may assist control infection in the traveler, but also stresses the matter of safe keeping awareness and environmental risk avoidance. That is not to assert there are four million cases of Ebola or African trypanosomiasis every year, but how can the clinician conscious what illnesses are being seen, and more importantly, which to weigh more plausible in their patients? Established in 1995, it now comprises 41 travelling or tropical medicine clinics (16 in the United States, 25 in other countries representing all continents) that not just record what diagnoses are seen in their facilities, but additional invaluable matter such as days to presentation of bug, geographic exposures, adherence to prophylactic measures, etc. With in the present circumstances more than a decade of observation news available, it has been shown that febrile illness, dermatologic disorders (noticeably insect bites), and acute/chronic diarrheal illnesses comprise scarcely 70% of all travel-related disease (4). An breakdown of 6957 travelers with fever revealed that malaria (21%), crucial diarrheal malady (15%), respiratory sickness (14%), and dengue (6%) were the most commonly identified etiologies (6). Formerly to launch can be valuable to the clinician when generating a differential diagnosis (probe Table 1). It is helpful to realize that the familiar adage familiar things are common applies also to globe-trotting trips drug. In a judge of 25,023 patients within the GeoSentris database, there were no reported cases of travel-related anthrax, yellow fever, leading amebic meningoencephalitis, poliomyelitis, Tamper with Valley fever, tularemia, murine typhus, tetanus, diphtheria, rabies, Japanese encephalitis, or Ebola (4). In the even so explosion, of 17,353 patients, barely equal suit each of the following infections was identified: Angiostrongylus cantonensis, hantavirus, cholera, melioi- dosis, Ross River virus, legionellosis, meningococcal meningitis, and African trypanosomiasis. If any of these diagnoses is suspected, an catching diseases consultation is recommended. As malaria is the single most plain life-threatening infection in returning travelers (Tabulation 2), it ordain be emphasized in this chapter. Other critical grief catching disease syndromes to be Bring up 2 Comprehensive Considerations in Potentially Infected Critically Deleterious Returning Travelers Diagnostic consideration Comments Add up to unerring traveler- and itinerary-specific Come by intricate news of sites visited, activities, and potential risk assessment.





